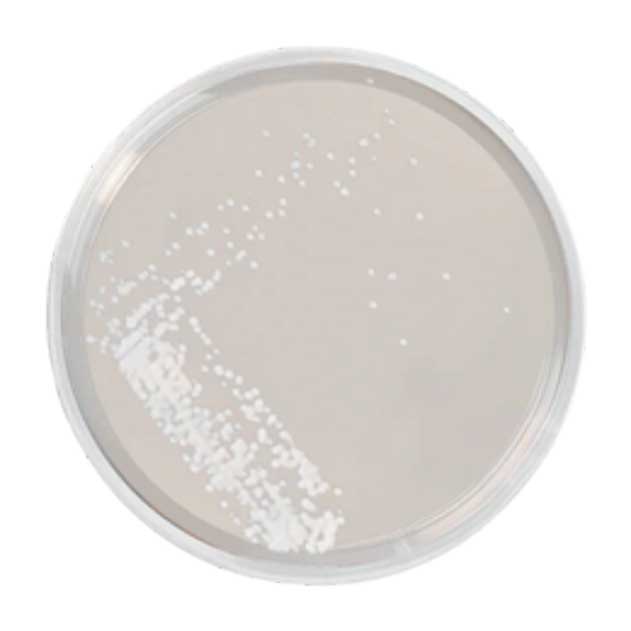

Convenient Access to Commonly Used Lab Materials
Q Laboratories offers a selection of commonly used testing supplies to support your sampling and laboratory workflows. These items are available for purchase directly through our team. For pricing and availability, please contact us.

General Testing Supplies

IDEXX Bottle
(120 mL polystyrene sample vessel with 100 mL fill line and tamper-evident label)

Culturette Swab
(Thermo Scientific™ BactiSwab™ Liquid Stuart Plastic Shaft)

PUR-Blue™ Dry Swabs
(Medical grade polyurethane foam tip)

TOC Swabs
(Texwipe Low TOC Alpha Sampling Swabs, long handle – 20 count)

TOC Vial
(Clear glass vial for TOC sampling)
SDA Air Settle Plate
(Thermo Scientific™ Sabouraud Dextrose Agar)

TSA Air Settle Plate
(Thermo Scientific™ Remel™ Tryptic Soy Agar)

EZ Reach™ Sponge Sampler
(Single poly sponge with LB and bag)

EZ Reach™ Split-Sampler LB
(Dual sponge samplers with bendable handles)

Sterile Nitrile Gloves
(Kimtech™ G3 Sterile White Nitrile Gloves)

Whirl-Pak® Bag
(55oz Homogenizer Blender Filter Bag)

4oz Sterile Scoop
(Sterileware® plastic scoop)

250mL Legionella Bottle
(Polyethylene with Sodium Thiosulfate and tamper-evident label)

1L Legionella Bottle
(Polyethylene with Sodium Thiosulfate and tamper-evident label)



